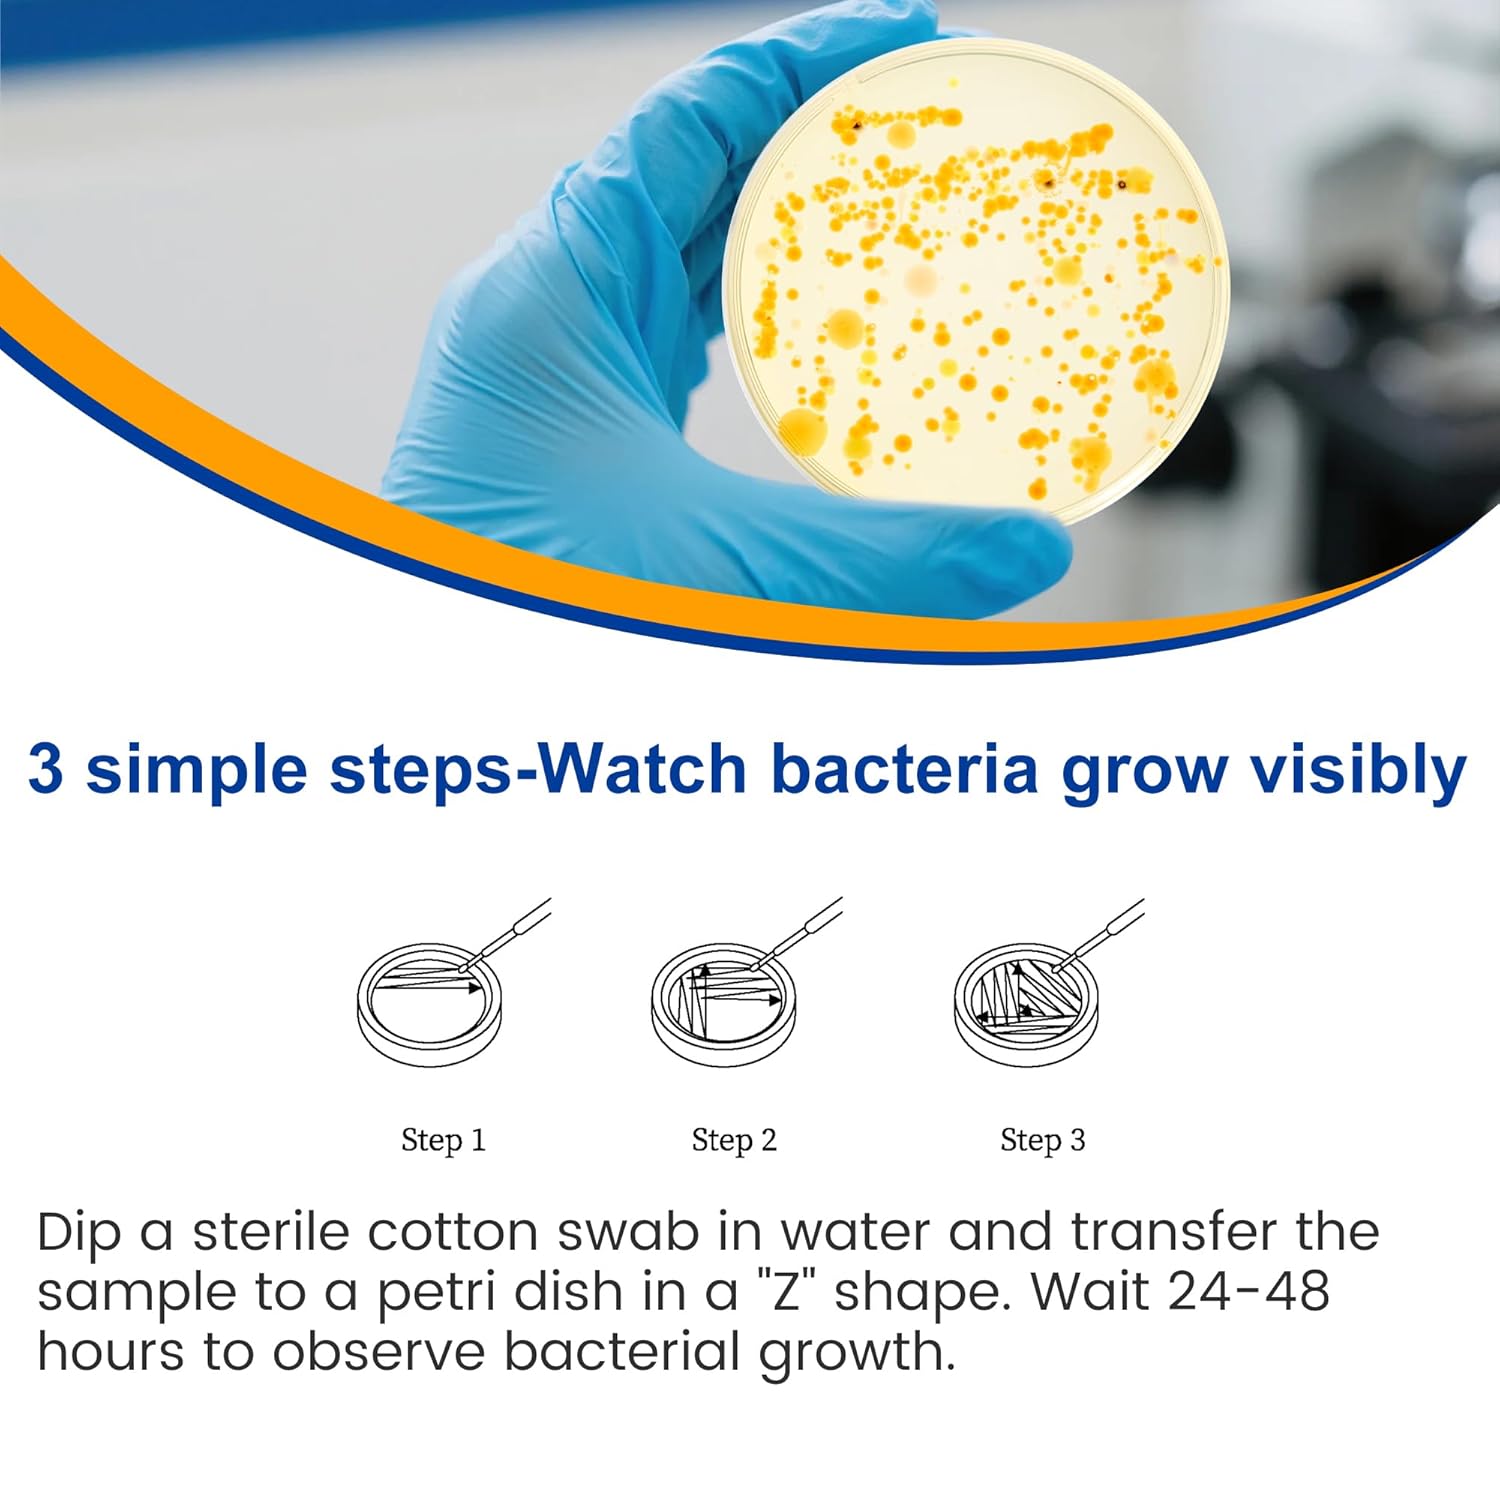

New
Arrivals/Restock
Bacteria Test Kits for Drinking Water - 12 Tests Detect Coliform, E.coli & All Bacteria | Home Quality Testing Kit for Well, Tap, Pool, Hot Tub & City Water | Easy DIY Tester with Free Lab Analysis
 Limited Time Sale
Limited Time SaleUntil the end
16
19
36
US$16.79 cheaper than the new price!!
Free shipping for purchases over $99 ( Details )
Free cash-on-delivery fees for purchases over $99
Free cash-on-delivery fees for purchases over $99
See all stores
Please note that the sales price and tax displayed may differ between online and in-store. Also, the product may be out of stock in-store.
Used US$11.20
Product details
| Management number | 216928745 | Release Date | 2026/04/19 | List Price | US$11.20 | Model Number | 216928745 | ||
|---|---|---|---|---|---|---|---|---|---|
| Category | |||||||||
- 【Complete Water Testing Kit】- The Funhaosta Bacteria Test Kit includes 12 culture plates, detailed testing instructions, a bacterial identification guide with treatment recommendations, 12 sterile swabs, labeling stickers, testing gloves, and sealable bags. Everything is included - no additional supplies required!
- 【Accurate Test Results】- Unlike color-changing test strips, our kit allows you to visually observe bacterial growth within 24-48 hours on the culture plates, providing more reliable and verifiable results.
- 【Universal Water Testing】- Safely test all water sources including tap water, well water, pool water, aquariums, and more. Perfect for homes, RVs, camping trips, and outdoor use to ensure your water is bacteria-free.
- 【Detects ALL Bacteria】- Comprehensive testing for total bacterial contamination - not just E.coli/coliform. Identifies harmful bacteria like Salmonella, Staphylococcus aureus, Pseudomonas aeruginosa, and other common waterborne bacteria.
- 【FREE Expert Analysis】- Can't identify the bacteria? Simply send us clear photos of your culture plates for professional analysis. No need to mail samples - we'll provide a detailed bacteria analysis report!
- 【Water Safety Assurance】- Funhaosta's professional testing kit gives you peace of mind by ensuring your family's water safety. Our complete bacterial detection system helps prevent waterborne illnesses, protecting what matters most - your health and your loved ones.
| Brand Name | Funhaostar |
|---|---|
| Unit Count | 12.0 Count |
| Material Type | Agar, Cotton/Polyester |
| Recommended Uses For Product | Aquarium, Home Water, Pool Water, Tap Water, Well Water |
Correction of product information
If you notice any omissions or errors in the product information on this page, please use the correction request form below.
Correction Request Form